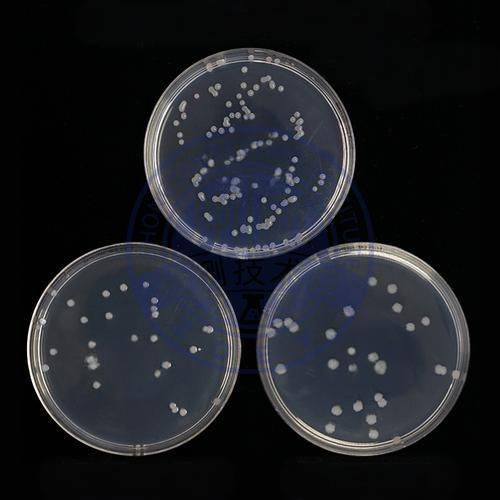
地衣芽孢杆菌检测

- 拨打服务热线:156-0036-6678
- 公司邮箱:zhongyan@admin.com



一、核心检测方法荧光定量PCR技术探针法(TaqMan)通过特异性引物与...
[查看详情]
一、菌种鉴定与分类显微观察法通过光学或电子显微镜直接观察复合菌的菌体结构,识...
[查看详情]
蛋白残留检测技术体系与质量控制一、核心检测方法免疫学检测法酶联免疫吸附法(...
[查看详情]
检测样品血清样品,尿液样品,唾液样,品脑脊液样品,组织样品,细胞培养液样品,毛发...
[查看详情]
检测样品硫酸钡,氯化钡,硝酸钡,碳酸钡,氢氧化钡,氟化钡,亚硫酸钡,亚硝酸钡,亚...
[查看详情]
地衣芽孢杆菌检测...
[查看详情]
检测样品新鲜鸡粪,干燥鸡粪,发酵鸡粪,生物堆肥鸡粪,有机鸡粪,无机鸡粪,堆肥鸡粪...
[查看详情]
梭菌检测...
[查看详情]我们的客户
我们出具的报告
我们的专业人员
我们专业的实验仪器